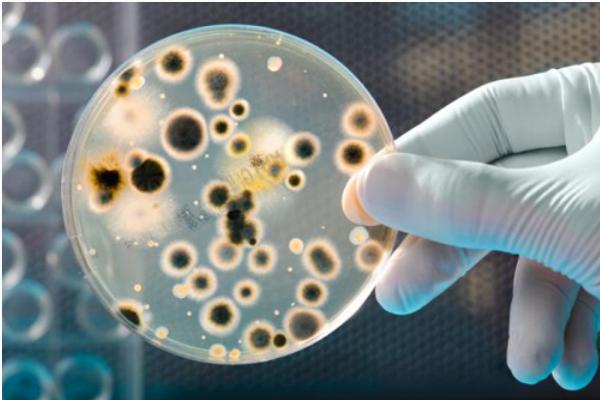
牛蛙有寄生虫吗?

牛蛙有寄生虫吗?
寄生虫这三个字足以让人们望而止步,大家都怕寄生虫,因为寄生虫它会危害人的身体,很多动物都带有寄生虫,所以在吃动物的时候必须要煮熟煮透,千万别去刻意强求肉质的鲜嫩,没有经过高温寄生虫是杀不死的。下面来看看大家经常吃到的牛蛙有同有寄生虫。

牛蛙有寄生虫吗
牛蛙自身有寄生虫等,如果清理不干净,或者煮不熟反而有害。吃火锅,经过高温来煮的话,细菌一般都杀死了,还有你吃的牛蛙一般都是人工养殖的,这样的话,是寄生虫很少的,加上做菜的时候经过高温煮熟了,是没有寄生虫的。
牛蛙的皮能吃吗
牛蛙的皮是可以吃的。用开水将牛蛙皮烫洗一边,洗掉表面的那一层粘杂物,然后充分煮熟就可以了。

不过一般情况下,我们不建议吃牛蛙皮,因为牛蛙皮带有的寄生虫比较多,处理不好的话就很容易引起一些疾病了。不想浪费的话可以把牛蛙皮留着作为药用。
如何预防寄生虫
人类想完全隔绝寄生虫又是不可能的。但寄生虫也有对人类有益的一面。对于一些遭受自身免疫力过强疾患的病人来说,寄生虫是一剂良方。寄生虫为了自身生存,会分泌一些化学物质,降低人体的免疫力。这种寄生虫药方,服用间期长,药效比化学药物要好。据BBC称,全球有14亿人受到寄生虫危及健康的威胁。而每个人身上都“栖息”有过100万只寄生细菌,昆虫。特别是在卫生条件较差的非洲和亚洲,蚊子猖獗,饮用水污染严重,人民营养不良,可见到丝虫引起的象皮病等寄生虫疾病。

1、饭前便后要洗手。
1993年美国一医院分析一些来自一犹太社区的血液样本,发现其中很多人感染上了猪肉绦虫。但是犹太教徒并不吃猪肉,原因何在?原来是每个受感染的犹太家庭都请过家务人员,正是这些家务人员个人卫生意识淡薄,加之这些家庭的饮食方法,导致了很多人感染了猪肉绦虫。
2、注意个人卫生,勤洗澡。
3、彻底煮熟肉类,海产食物。饮用水要彻底烧开。例如弓形虫,人类通过未彻底煮熟的肉类感染。世界人口有1/3感染,德国人也有50%的感染率。而喜欢吃不彻底煮熟的肉类的法国人,感染率达80%。
4、消灭蚊子等传播疾病的昆虫。
5、感染寄生虫后,及时就医。比如昏睡症的治疗,尽早治疗是康复的关键。
牛蛙的价值
牛蛙全身都是宝,是集食用、药用和皮用于一身的大型经济蛙类。牛蛙肉是上乘美味食品和高级的保健药膳,是一种高蛋白、低脂肪、低胆固醇的健康食品;同时,牛蛙肉还有很高的药用价值,其性平、味甘,具有滋补解毒的功效,夏季食用可避免皮肤生疮毒,手术患者食用可促进伤口愈合,肝、肺病患者食用可明显增进食欲。

此外,牛蛙皮是优质的乐器材料,上等的制革原料,还可提炼高级豁胶;牛蛙油可制优质油脂,牛蛙脑垂体是高效的催产激素,牛蛙的下脚料可制优质饲料。牛蛙还是良好的实验动物,是忠实的植保卫士。人工养殖牛蛙生长快,产量高,成本低,价值高,具有很高的经济效益。
青蛙、牛蛙、田鸡的区别
青蛙是黑斑蛙;牛蛙就是牛蛙;田鸡是虎纹蛙。
田鸡并不是野生青蛙,虎纹蛙才是真正意义上的田鸡。由于黑斑蛙(青蛙)和虎纹蛙如果不仔细区分很难观察清楚,同时二者也有些相仿,于是田鸡在南方人中也就成了对青蛙的称呼,就好比东北人把玉米称为苞米一样,其实玉米也有很多种类的。

青蛙是不能吃的,但是养殖的牛蛙是可以食用的,虽然有可能带有寄生虫,但是经过处理,以及高温煮熟是可以杀死寄生虫的。当然不管是饮食还是生活中大家都一定要注意卫生,预防寄生虫。









